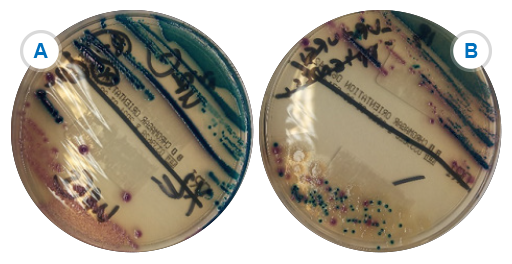
Described image

3.2 Chromogenic media
Chromogenic media, first mentioned in Section 2.1, are useful in certain situations, for example to identify:
- organisms in potentially mixed samples – if you have a lot of samples to test (see Figure 3)
- specific species with a reasonable level of accuracy without the need for additional testing
- resistant strains/species.
Whilst expensive, this relatively new media type saves a lot of time in laboratories that deal with large numbers of routine urine samples.
Activity 9: Species identification
In Figure 3B, Klebsiella and Enterobacter look the same (metallic blue) and for clinical purposes are usually reported as ‘coliform species – non-E. coli’. However, for management and for surveillance purposes, it may be necessary to identify K. pneumoniae from other coliforms, particularly if there is concern about MDR strains of K. pneumoniae.
What options would you have to differentiate the Klebsiella species from other non-E. coli coliforms?
If you are not able to answer this question now, you can return to it after having studied other sections of this course.
Discussion
- API20E,
MALDI-TOF (see Section 3.3.1), and automated systems would all be able to differentiate these bacteria. However, if none of these is available, motility and biochemical tests are performed. Although these two organisms are very similar Enterobacter is motile whereas Klebsiella is not so the motility test is a useful way of discriminating between them. - The additional tests might be too time-consuming and/or expensive to do on every isolate just for surveillance. However, if the tests are not done then this could potentially be a source of bias and error in AMR data.
- One option is to send the isolate to a reference laboratory for testing, but if only the more resistant isolates are sent this would again be a potential source of bias and error in AMR data.
- A better option might be to implement a sampling framework where a proportion of isolates received by the laboratory are identified for AMR surveillance purposes.
3.1 Biochemical test strips